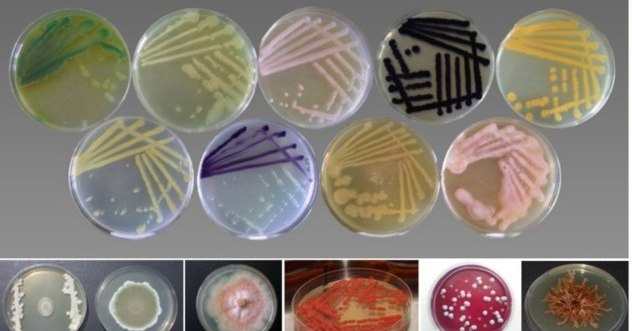

MIRRI_IT
@itmirri
The Joint Research Unit MIRRI-IT is a formal collaboration among interested bodies aimed at the creation of the Italian node of MIRRI-ESFRI
ID: 1010518783847469056
http://www.mirri-it.it/ 23-06-2018 13:43:47
147 Tweet
136 Followers
69 Following


New position available at the Colecciรณn Espaรฑola de Cultivos Tipo (CECT) to work on the project BIOINDUSTRY 4.0 "RI services to promote deep digitalization of Industrial Biotechnology - towards smart biomanufacturingโ, funded by Horizon Europe #jobpost



๐ฃ3rd day of the International Conference on Culture Collections is happening today at Universidade Minho ๐๏ธToday IS_MIRRI21 partners are gathered at the General Assembly to present the project results and discuss key outcomes and challenges #IS_MIRRIย #MIRRI_ERICย #IS_MIRRI21





The ECCO Board thanks you for participating in the #ECCOXLI meeting ๐ง๐ช See you next year in Bari, Italy ! ๐๐ฎ๐น Gerard Verkley, Giovanna Cristina Varese, @LualAyuen, Raquel Hurtado-Ortiz, Wouter De Schamphelaire, Pekka Oivanen



๐๐๐ ๐ ๐๐ ๐ ๐๐๐๐๐๐๐๐ ๐ ๐๐๐๐ ๐๐๐ ๐๐๐๐๐๐๐๐๐๐ SUS-MIRRI has developed Standard Operating Procedures for solid and liquid #FermentedFoods Download SOPs here ๐ for free! zenodo.org/record/8430600 Follow us to stay updated! #MicrobialDiversity #microbiology

๐ฃRecalling this summerยดs ๐๐ง๐ญ๐๐ซ๐ง๐๐ญ๐ข๐จ๐ง๐๐ฅ ๐๐จ๐ง๐๐๐ซ๐๐ง๐๐ ๐จ๐ง ๐๐ฎ๐ฅ๐ญ๐ฎ๐ซ๐ ๐๐จ๐ฅ๐ฅ๐๐๐ญ๐ข๐จ๐ง๐ฌ ๐๐๐๐๐15 ๐๐จ๐๐๐ฅ ๐๐ซ๐ ๐๐ง๐ข๐ณ๐ข๐ง๐ ๐๐จ๐ฆ๐ฆ๐ข๐ญ๐ญ๐๐ just shared the digital Abstract Book ๐ismirri21.mirri.org/2023/12/06/iccโฆ



๐ขOpen call for a Project Manager to coordinate and manage tasks derived from the participation of Colecciรณn Espaรฑola de Cultivos Tipo (CECT) in MIRRI-ERIC Main activities will be related to the Microbes4Climate EU project Apply by 31 May at links.uv.es/x5U5Le4 #jobopportunity #job #hiring #jobvacancy


